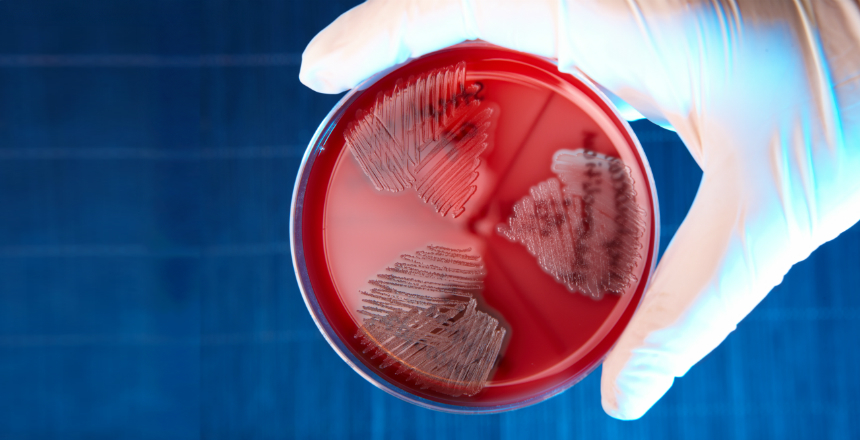
Фото - Инфекции в период беременности. Выявление стрептококка группы В

Инфекции в период беременности. Выявление стрептококка группы В
16.05.2017Инфекции в период беременности, которые могут передаваться от матери плоду заслуживают большого внимания, так как несут потенциальный риск заражения плода или новорожденного и могут приводить к нежелательным последствиям. Кроме того, диагностика инфекций во время беременности имеет определенные особенности за счет асимптоматического течения большинства материнских инфекций или неспецифичности признаков и симптомов.
Стрептококк группы В (СГВ, GBS, Streptococcus agalactiae) - вызывает тяжелые заболевания новорожденных и представляет опасность для определенных пациентов других возрастных групп.
Установлено, что СГВ у 30% беременных женщин можно обнаружить во влагалище и часто в уретре их половых партнеров. Несмотря на то, что СГВ могут встречаться как часть нормальной микрофлоры кишечника женщины, колонизация ими урогенитального тракта беременной представляет значительную опасность для плода за счет возможности возникновения восходящей инфекции. Существует достоверная связь носительства СГВ во влагалище не только с ранним инфицированием новорожденных (сепсис, пневмония и менингит), но и с преждевременными родами, преждевременным отхождением околоплодных вод, мочевой инфекцией у беременных, развитием хориоамнионита во время родов, эндометритом.
В США, Канаде и странах Европы приняты регламентированные Национальные программы профилактики и лечения СГВ-инфекций, обязательные для исполнения всеми медицинскими учреждениями.
С 01.05.17 г. МЛ ДIЛА внедряет новое исследование «Выявление стрептококка группы В (streptococcus agalactiae) с чувствительностью к антибиотикам».
|
Своевременное выявление беременных, положительных на наличие стрептококка группы В и тех, которые имеют факторы риска увеличения вероятности инфицирования новорожденного позволяет провести в/в антибиотикопрофилактику с началом родовой деятельности и предупредить раннее инфицирование новорожденного стрептококком группы В:
|
Правила подготовки: за 24 часа исключить использование интровагинальных и ректальных медикаментозных препаратов, перед взятием биоматериала не проводить туалет наружных половых органов.
Взятие биоматериала выполняется из двух точек: нижняя треть влагалища и следующая - rectum, оценивается общий результат.
Выявление стрептококка группы В проводится культуральным методом с определением чувствительности к антибиотикам.
Срок выполнения исследования: 6 дней (Киев), 7,5 дней (Регионы).
Адекватная оценка риска инфицирования новорожденного стрептококком группы В позволит существенно сократить возможность развития осложнений и обеспечить благоприятный исход беременности.
Литература:
1. Australasian society for infectious diseases, 2014
2. Antibiotic Prevention for Maternal Group B Streptococcal Colonization on Neonatal GBS-Related Adverse Outcomes: A Meta-Analysis, Shunming Li, Jingya Huang, 2017.
3. Early onset Group B Streptococcal disease Queensland clinical guidelines, 2016
4. Влияние стрептококков группы B, колонизирующих урогенитальный тракт беременных, на течение и исход беременности / Оганян К.А., Зациорская С.Л., Аржанова О.Н., Савичева А.М. – Санкт-Петербург, 2014
5. Дайджест профессиональной медицинской информации. Врожденные и перинатальные инфекции: предупреждение, диагностика и лечение. / Catherine S. Peckham. - № 1 (4). – 2008.